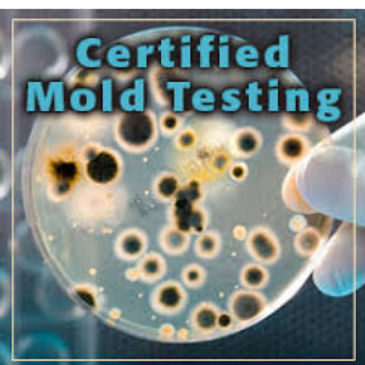

Specialty Inspection Services
mold testing
LEAD AND ASBESTOS TESTING
LEAD AND ASBESTOS TESTING
The presents of Mold Growth in the home can cause serious health issues in addition to causing serious structural damage to the home. Your trained Advantage Inspector can check for hidden mold growth using specialized air sampling equipment and can also provide mold surface sample testing for visible mold issues. We work with accredited l
The presents of Mold Growth in the home can cause serious health issues in addition to causing serious structural damage to the home. Your trained Advantage Inspector can check for hidden mold growth using specialized air sampling equipment and can also provide mold surface sample testing for visible mold issues. We work with accredited laboratories to provide fast and professional lab results for our clients.

LEAD AND ASBESTOS TESTING
LEAD AND ASBESTOS TESTING
LEAD AND ASBESTOS TESTING
Exposure to either Lead or Asbestos can lead to serious health issues. Your trained Advantage Inspector can provide professional surface sample testing in partnership with accredited laboratories to identify risks of either Lead or Asbestos and protect your health and home.

AIR QUALITY TESTING
LEAD AND ASBESTOS TESTING
AIR QUALITY TESTING
Poor Indoor Air Quality can cause serious respiratory issues and disease including asthma. Air quality testing performed by a trained Advantage Inspector, in partnership with accredited laboratories, examines biological pollutants like mold, bacteria, dust mites, and pollen in the air to help you understand and mitigate these health risks in your home.
About Advantage Home Inspections

WATER QUALITY TESTING
WATER QUALITY TESTING
WATER QUALITY TESTING
Coming Soon

SEPTIC INSPECTION
WATER QUALITY TESTING
WATER QUALITY TESTING
Coming Soon

WELL INSPECTION
WATER QUALITY TESTING
WELL INSPECTION
Coming Soon
Schedule Your Inspection
Copyright © 2023 Advantage Home Inspections - All Rights Reserved.
